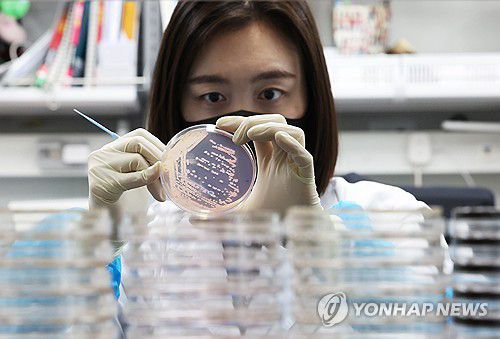
연합뉴스

범정부 식중독대책협의회 고위급 회의 개최
|
식중독 조심하세요 |
(서울=연합뉴스) 유한주 기자 = 식품의약품안전처는 청주오스코에서 관계부처·지자체·협회 등이 참여하는 2026년도 범정부 식중독대책협의회 고위급 회의를 개최하고 식중독 예방대책을 논의했다고 24일 밝혔다.
올해 정부는 AI(인공지능) 및 과학 기반 식중독 안전관리 체계 구축, 생선부터 소비까지 빈틈없는 식중독 관리, 최신 추세를 반영한 맞춤형 교육·홍보를 추진한다.
구체적으로는 AI 식중독 원인추정시스템을 개발 및 운영하고 AI 기반 식중독 예측 지도 서비스를 제공한다.
식중독 발생 농장 및 취급 업체의 달걀 검사를 강화하고 노로바이러스 상시 감시 대상도 확대한다.
지역 축제·행사 식음료 안전관리 체계도 구축한다.
이와 함께 식품 안전 마라톤 대회를 개최하고 어린이와 학부모 등을 대상으로 하는 식중독 예방 교육에 힘쓴다.
김용재 식약차장은 "최근 기후·식생활 트렌드 등이 급격히 변화하고 있는 만큼 데이터와 과학에 기반한 예방 중심의 관리체계를 강화해야 한다"고 말했다.
hanju@yna.co.kr
▶제보는 카카오톡 okjebo
▶연합뉴스 앱 지금 바로 다운받기~
▶네이버 연합뉴스 채널 구독하기
<저작권자(c) 연합뉴스, 무단 전재-재배포, AI 학습 및 활용 금지>
이 기사의 카테고리는 언론사의 분류를 따릅니다.
기사가 속한 카테고리는 언론사가 분류합니다.
언론사는 한 기사를 두 개 이상의 카테고리로 분류할 수 있습니다.
언론사는 한 기사를 두 개 이상의 카테고리로 분류할 수 있습니다.


